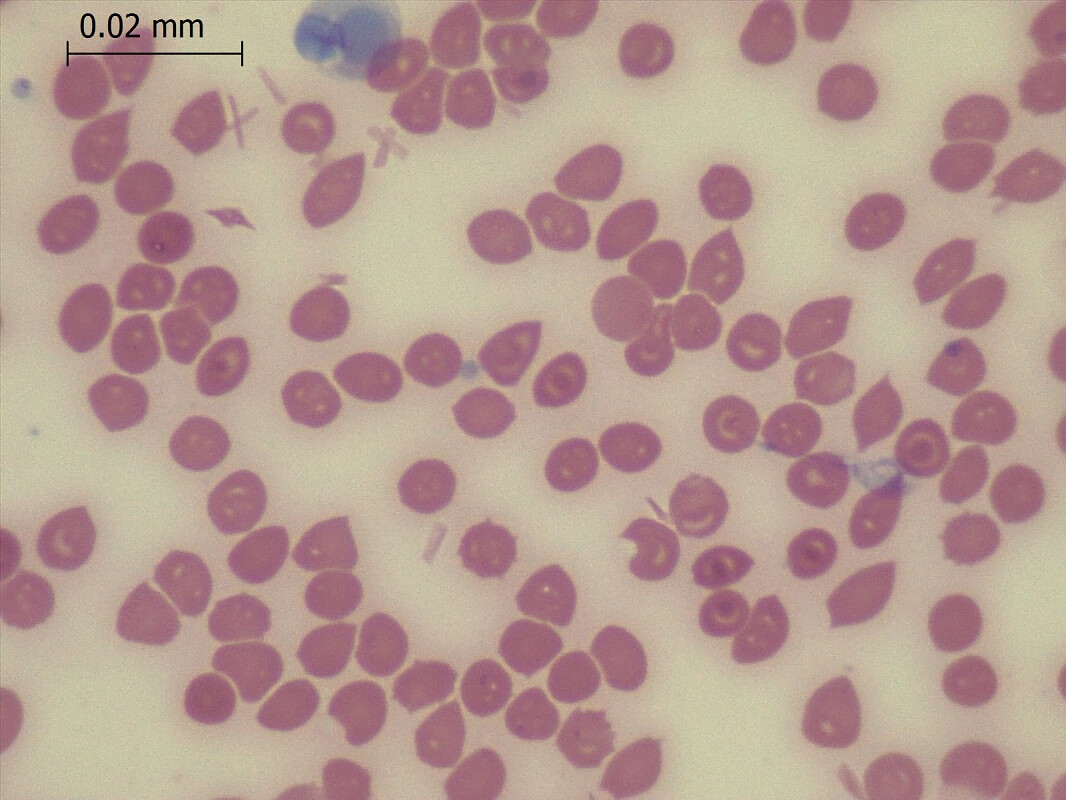
定制适用于diffquick迪夫快速细胞染色液固定液 排卵分泌物涂片现 3款

细胞固定液

4%组织细胞固定液 - 迈基生物
图片尺寸991x1212
组织固定液(中性)4% 细胞固定液 g1101 白鲨 瓶装500ml
图片尺寸800x800
改良贝林(balling)固定液(细胞分裂) 3x500ml 科研实验试剂 现货
图片尺寸1080x1080
x 选择合适的固定方法对于免疫细胞化学技术是十分重要的.
图片尺寸600x366
10%中性福尔马林固定液病理组织甲醛标本保存38%养殖水产消毒溶液
图片尺寸800x800
03 搜索:福尔马林固定液
图片尺寸800x800
组织固定液(含醛型)
图片尺寸1080x1144
定制适用于diffquick迪夫快速细胞染色液固定液 排卵分泌物涂片现 3款
图片尺寸1066x800
bouins固定液
图片尺寸2448x2448
500g1%兔红细胞(1000x)支原体清除剂戊二醛固定液(4%) 500mlack红细胞
图片尺寸1024x768
4%多聚甲醛固定液
图片尺寸800x800
组织细胞固定液组化生物实验/盐ph7.4溶液(4% pfa) 250ml
图片尺寸800x800
faa固定液aaf固定液7050植物组织500mlph0974phygenefaa固定液500ml50
图片尺寸350x350
gs组织标本固定液
图片尺寸500x500
ams0001,4%多聚甲醛(通用型组织固定液),500ml
图片尺寸2835x2835
细胞保存液
图片尺寸800x533
卡诺氏固定液(用于固定肠道粘液)
图片尺寸600x427
biosharp组织固定液 4%多聚甲醛/通用型组织固定液 白鲨易实验耗材
图片尺寸800x800
比克曼生物 迪夫快速细胞染色液固定液显微镜生物涂片染色剂 迪夫染色
图片尺寸800x800
福尔马林10%中性组织固定液病理送检标本保存
图片尺寸750x750